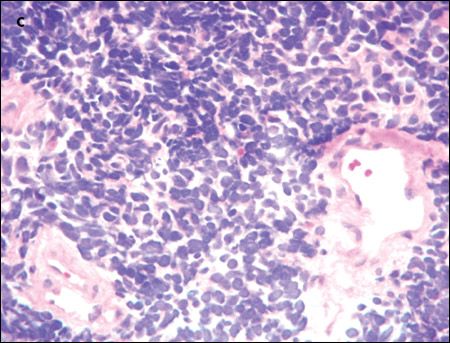
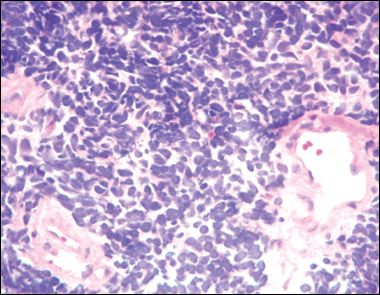

A 71-year-old African American man presented to the emergency department (ED) with chest pain, dyspnea, and hemoptysis. He had had a few ED visits for similar symptoms within the previous 4 weeks.

A 71-year-old African American man presented to the emergency department (ED) with chest pain, dyspnea, and hemoptysis. He had had a few ED visits for similar symptoms within the previous 4 weeks.
The patient had hypertension and a 40-pack-year smoking history; he currently smoked. There was no family history of malignancy.
Temperature was 36.8°C (98.3°F); heart rate, 86 beats per minute; respiration rate, 24 breaths per minute; and blood pressure, 120/70 mm Hg. Oxygen saturation was 98% on 2 liters of oxygen. Oral thrush was evident. There was no palpable lymphadenopathy. Heart rhythm was irregular with a loud P2; there were no appreciable murmurs. Chest examination showed diffuse bilateral wheezes and dullness to percussion at both lung bases. There was no palpable hepatomegaly or splenomegaly. No pedal edema was noted. Results of a neurological examination were nonfocal.

White blood cell count was 3200/μL; hemoglobin level, 15.9 g/dL; and platelet count, 54,000/μL. The absolute neutrophil count was 900/μL. A chemistry panel revealed the following levels: sodium, 136 mEq/L; potassium, 3.4 mEq/L; chloride, 91 mEq/L; creatinine, 1.04 mg/dL; and calcium, 9.5 mg/dL. His coagulation profile showed a partial thromboplastin time of 28 seconds and an international normalized ratio of 1.0.
A CT scan of the chest showed an amorphous soft tissue mass that encased and constricted the right main pulmonary artery and the right main stem bronchus (A). Extensive round masses were visible in the liver; the largest mass was in the right medial hepatic lobe and measured 2.7 × 2.4 cm (B).
An extensive evaluation of the patient's mass lesions and cytopenias was initiated. He was HIV-positive, but results of tests for hepatitis B and C were negative. Liver function tests revealed the following levels: albumin, 3.1 g/dL; total protein, 5.8 g/dL; direct bilirubin, 0.3 mg/dL; total bilirubin, 1.0 mg/dL; alkaline phosphatase, 175 U/L; alanine aminotransferase, 156 U/L; and aspartate aminotransferase, 92 U/L. Haptoglobin level was 27 mg/dL, and lactate dehydrogenase level was elevated at 1168 U/L. The fibrinogen level was normal at 274 mg/dL, but the D-dimer level was elevated at 602 ng/mL. Results of an enzyme-linked immunosorbent assay for heparin-induced platelet antibodies were negative. A review of the peripheral smear (C) showed no platelet clumping, schistocytes, or immature cells. Blood and urine cultures showed no bacterial or fungal growth.
Answer: B. Small-cell lung cancer

The central location of the lung mass, its rapid growth, and the patient's strong smoking history all pointed to small-cell lung cancer, B. Also, there is a noted propensity for bone marrow involvement in small-cell lung cancer, which might have explained the patient's neutropenia and thrombocytopenia.
FURTHER WORKUP
Tissue was needed to confirm the diagnosis. The patient received a transfusion of 1 pool of platelets so that a CT-guided liver biopsy could be performed. The results of this biopsy were nonconclusive. However, his platelet count rose dramatically in response to the transfusion-to 150,000/μL.
The patient then underwent a diagnostic bronchoscopy and a biopsy of the lung mass. The lung mass biopsy demonstrated small-cell lung carcinoma; immunohistochemical stains were positive for the neuroendocrine markers AE1/AE3, CAM5.2, cytokeratin 7 (CK7), thyroid transcription factor-1 (TTF-1), synaptophysin, chromogranin A, and CD 56.

OUTCOME OF THIS CASE
Unfortunately, his condition deteriorated during the hospital stay. His mental status started to wax and wane, progressive azotemia developed, and his neutropenia and thrombocytopenia continued to worsen. After a thorough discussion with the patient and his family, it was decided that he would not receive therapy for his cancer. He was transferred to an inpatient hospice service, and he died within 1 day.
SMALL-CELL LUNG CANCER: AN OVERVIEW
There are 2 major forms of lung cancer: small-cell lung cancer (SCLC) and non–small-cell lung cancer (NSCLC). SCLC accounts for a minority of lung cancer cases, and its incidence has gradually decreased over the past few decades. A Surveillance, Epidemiology, and End Results (SEER) database analysis has shown a decrease in the proportion of lung cancer cases represented by SCLC, from 17% in 1986 to 13% in 2002.1 SCLC occurs mostly in heavy smokers. The decrease in the incidence of SCLC can be explained by the reduction in the rates of cigarette smoking in the United States.1
SCLC is characterized by a high growth fraction, a rapid doubling time, and a propensity for early metastasis. Multiple classification systems for SCLC have been proposed. The most recent 1999 World Health Organization/ International Association for the Study of Lung Cancer (WHO/IASLC) classification divides SCLC into 3 groups.
Multiple genetic abnormalities have been described in SCLC. The most common of these are the p53 mutation, loss of heterozygosity at chromosome arms 9q and 10q, and loss of retinoblastoma gene function.4,5
SCLC STAGING
There are 2 major staging systems for SCLC. The one most commonly used is the Veterans Affairs Lung Study Group system, which divides SCLC into limited-stage disease and extensive-stage disease. Limited-stage disease is defined as disease confined to the ipsilateral hemithorax and within a single radiotherapy port. Extensive-stage disease is defined as evident metastatic disease outside the ipsilateral hemithorax; this may include malignant pleural or pericardial effusions.6 About 30% to 40% of patients have limited-stage SCLC at presentation. The other, more descriptive staging system, the TNM or IASLC system, is of limited value because of overlaps in treatment and prognosis among the various stages.
PARANEOPLASTIC SYNDROMES ASSOCIATED WITH SCLC
SCLC is associated with many endocrine and neurological paraneoplastic syndromes. The most common of these are:
Poll Results
Online Poll
Powered By
WebsiteGear
: Requires Javascript Enabled On Your Browser.
CLINICAL CHARACTERISTICS OF SCLC
SCLC typically presents as a large central mass (as in this patient) with mediastinal adenopathy. SCLC can infiltrate the submucosa, causing either intrinsic or extrinsic compression of the bronchi. SCLC has a propensity for spreading to the liver, brain, bone, and bone marrow. The neutropenia and thrombocytopenia seen in this man can be explained by the infiltration of his bone marrow by the SCLC. In a series of 129 patients with SCLC, 30% had bone marrow involvement. However, in only 2.3% was the bone marrow the only site of metastatic disease.7 Other presenting symptoms include cough, dyspnea, hemoptysis, chest pain, postobstructive pneumonia, and the paraneoplastic syndromes mentioned above.
SCLC TREATMENT
The standard of care for the treatment of limitedstage SCLC is cytotoxic chemotherapy and thoracic radiation, administered concurrently. The most common chemotherapy regimen is cisplatin plus etoposide.8 The standard of care for the treatment of extensive-stage SCLC is generally cytotoxic chemotherapy with etoposide and either cisplatin or carboplatin. Various other chemotherapeutic agents are active against SCLC, including topotecan, paclitaxel, docetaxel, irinotecan, adriamycin, cyclophosphamide, and vincristine. In addition, prophylactic cranial irradiation is now considered standard of care for both limited-stage and extensivestage SCLC.
SCLC is very sensitive to both chemotherapy and radiation; it responds well to treatment. However, in the majority of cases the disease recurs. Compared with its role in other forms of lung cancer, surgery has a very minimal role in the management of SCLC. There is only slight evidence to support surgery as a primary modality of treatment for limited-stage SCLC.
REFERENCES:
1.
Govindan R, Page N, Morgensztern D, et al. Changing epidemiology of small-cell lung cancer in the United States over the last 30 years: analysis of the surveillance, epidemiologic, and end results database.
J Clin Oncol
. 2006;24:4539-4544.
2.
Travis WD, Colby TV, Corrin B, et al.
Histological Typing of Lung and Pleural Tumors
. 3rd ed. Berlin: Springer-Verlag; 1999.
3.
Junker K, Wiethege T, Müller KM. Pathology of small-cell lung cancer.
J Cancer Res Clin Oncol
. 2000;126:361-368.
4.
Wistuba II, Gazdar AF, Minna JD. Molecular genetics of small cell lung carcinoma.
Semin Oncol
. 2001;28(2 suppl 4):3-13.
5.
Meyerson M, Franklin WA, Kelley MJ. Molecular classification and molecular genetics of human lung cancers.
Semin Oncol
. 2004;31(1 suppl 1):4-19.
6.
Guidelines for the treatment of small cell lung cancer.
http://www.nccn.org/professionals/physician_gls/f_guidelines.asp#site
.
7.
Tritz DB, Doll DC, Ringenberg QS, et al. Bone marrow involvement with small cell lung cancer. Clinical significance and correlation with routine laboratory variables.
Cancer
. 1989;63:763-766.
8.
Turrisi AT 3rd, Kim K, Blum R, et al. Twice-daily compared with once-daily thoracic radiotherapy in limited small-cell lung cancer treated concurrently with cisplatin and etoposide.
N Engl J Med
. 1999;340:265-271.